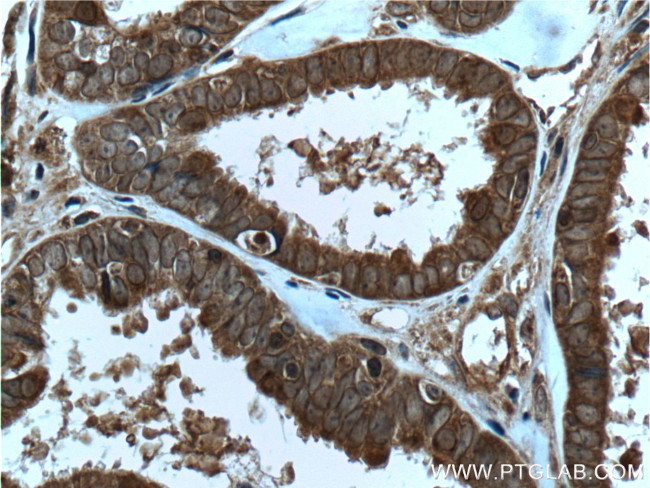
IL36 gamma Antibody in Immunohistochemistry (Paraffin) (IHC (P))

Search
Proteintech
IL36 gamma Polyclonal Antibody
{{$productOrderCtrl.translations['antibody.pdp.commerceCard.promotion.promotions']}}
{{$productOrderCtrl.translations['antibody.pdp.commerceCard.promotion.viewpromo']}}
{{$productOrderCtrl.translations['antibody.pdp.commerceCard.promotion.promocode']}}: {{promo.promoCode}} {{promo.promoTitle}} {{promo.promoDescription}}. {{$productOrderCtrl.translations['antibody.pdp.commerceCard.promotion.learnmore']}}
产品信息
24723-1-AP
种属反应
宿主/亚型
分类
类型
抗原
偶联物
形式
浓度
规格
纯化类型
保存液
内含物
保存条件
运输条件
产品详细信息
Immunogen sequence: MRGTPGDAD GGGRAVYQSM CKPITGTIND LNQQVWTLQG QNLVAVPRSD SVTPVTVAVI TCKYPEALEQ GRGDPIYLGI QNPEMCLYCE KVGEQPTLQL KEQKIMDLYG QPEPVKPFLF YRAKTGRTST LESVAFPDWF IASSKRDQPI ILTSELGKSY NTAFELNIND (1-169 aa encoded by BC098337)
靶标信息
Cytokine that binds to and signals through the IL1RL2/IL-36R receptor which in turn activates NF-kappa-B and MAPK signaling pathways in target cells. Part of the IL-36 signaling system that is thought to be present in epithelial barriers and to take part in local inflammatory response; similar to the IL-1 system with which it shares the coreceptor IL1RAP. Seems to be involved in skin inflammatory response by acting on keratinocytes, dendritic cells and indirectly on T-cells to drive tissue infiltration, cell maturation and cell proliferation. In cultured keratinocytes induces the expression of macrophage, T-cell, and neutrophil chemokines, such as CCL3, CCL4, CCL5, CCL2, CCL17, CCL22, CL20, CCL5, CCL2, CCL17, CCL22, CXCL8, CCL20 and CXCL1; also stimulates its own expression and that of the prototypic cutaneous proinflammatory parameters TNF-alpha, S100A7/psoriasin and inducible NOS. May play a role in proinflammatory responses during particular neutrophilic airway inflammation: activates mitogen-activated protein kinases and NF-kappa B in primary lung fibroblasts, and stimulates the expression of IL-8 and CXCL3 and Th17 chemokine CCL20 in lung fibroblasts. May be involved in the innate immune response to fungal pathogens, such as Aspergillus fumigatus.
仅用于科研。不用于诊断过程。未经明确授权不得转售。
生物信息学
蛋白别名: cytokine; IL-1H1; IL-1 epsilon; IL-1 related protein 2; IL-1-epsilon; IL-1-related protein 2; IL-1F9; IL-1H1; IL-1RP2; Interleukin; interleukin 1-related protein 2; Interleukin-1 epsilon; Interleukin-1 family member 9; Interleukin-1 homolog 1; Interleukin-36; Interleukin-36 gamma
基因别名: IL-1F9; IL-1H1; IL-1RP2; IL1E; IL1F9; IL1H1; IL1RP2; IL36G; UNQ2456/PRO5737
UniProt ID: (Human) Q9NZH8
Entrez Gene ID: (Human) 56300